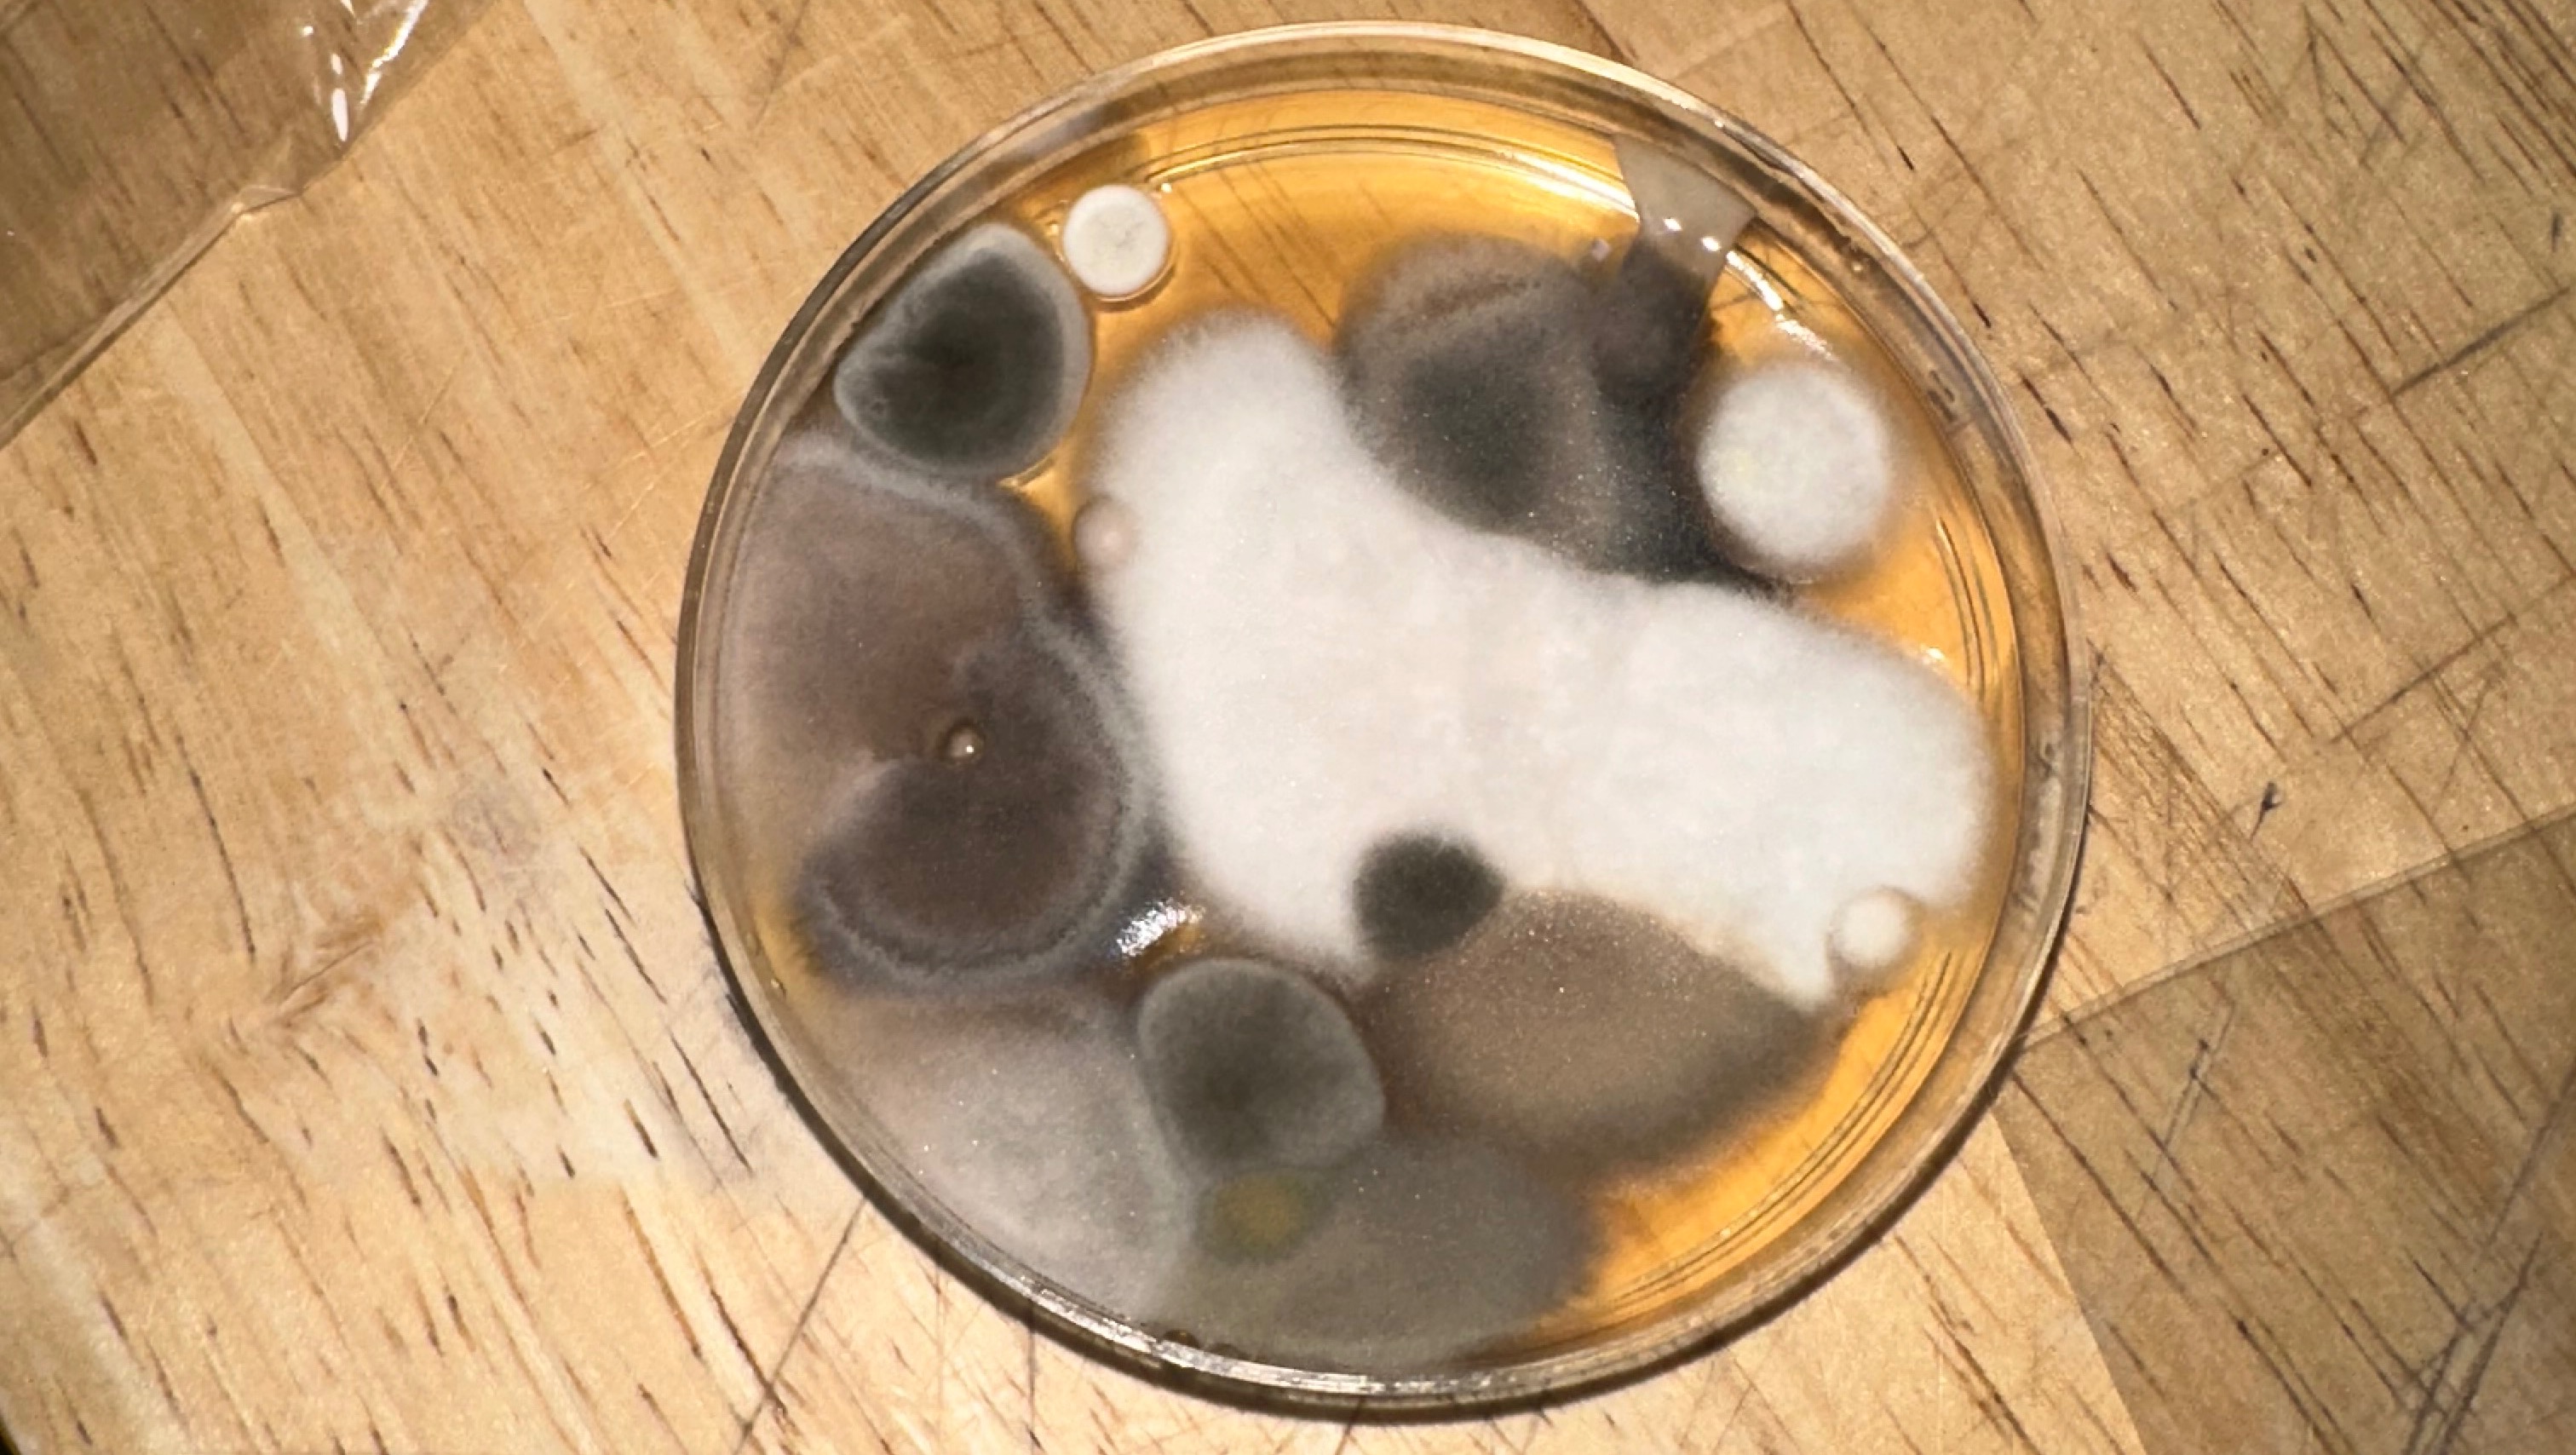

After putting my son to bed one night, I noticed a brown spot on the floorboard next to his crib. When I pulled up the floorboard to investigate, I discovered a massive black mold infestation that had been growing out of sight. The mold has spread into our bedroom from the bathroom and now we’re facing the daunting task of demolishing the bathroom, installing a new subfloor and shower, and removing everything that could of come in contact with the mold spores to include All the carpet in the area, and potentially our whole closet full of clothes to the mold spores.
This has been a huge shock for our family, especially with two young children—a 1-year-old son and a 4-year-old daughter—who need a safe place to live and shower. The funds raised will go directly toward repairs, replacing what we’ve lost, and making sure our home is free from toxic mold. Our top priority is to create a safe environment for our kids so they can be in a healthy environment.
I want to thank everyone who helps out , your kindness will not be forgotten. I know during the holiday season, money is tight for many so anny donation you make needs the world to us and our kids. From the bottom of our hearts, we just want to say thank you for considering our family. Your support means so much to us, god bless you!





